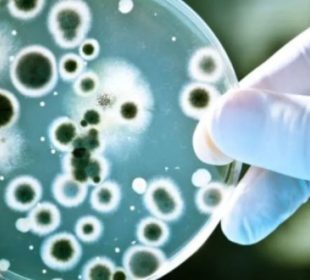

राष्ट्रीय
इन 11 राज्यों में फैली ये संक्रामक बीमारी, रोगियों में लिवर-किडनी फेलियर का खतरा, जानें ...
नई दिल्ली। तेज धूप के साथ गर्मी कहर बरपा रही है। तापमान में हो रहे उतार चढ़ाव की वजह से वायरल बीमारियों ...MODI 3.0 किसे मिली किस मंत्रालय की कमान और किसका बदला मंत्रालय, जानें पूरी लिस्ट…
MODI 3.0 किसे मिला कौन-सा पोर्टफोलियो: मोदी कैबिनेट में मंत्रियों के बीच पोर्टफोलियो का बंटवारा कर दिया गया है। जिसकी डिटेल्स आप ...अंतिम संस्कार कर गम मना रहा था परिवार, तेरहवीं के दिन अचानक लौट आया ‘मरा’ ...
मध्य प्रदेश। श्योपुर के लहचोड़ा गांव से एक हैरान करने वाला मामला सामने आया है। यहां जिस युवक का सड़क हादसे के ...PM Modi Cabinet : जानें कौन बना कैबिनेट मंत्री, किसे मिला स्वतंत्र प्रभार, देखें लिस्ट…
नई दिल्ली। भाजपा के वरिष्ठ नेता प्रधानमंत्री नरेन्द्र मोदी (Narendra Modi) ने रविवार को लगातार तीसरे कार्यकाल के लिए प्रधानमंत्री के रूप ...पिज्जा खाने से 11 साल की बच्ची की मौत, मचा हड़कंप
नई दिल्ली। बर्गर-पिज्जा जैसे फास्ट और जंक फूड्स के बच्चों से लेकर वयस्कों तक सभी दीवाने हैं। अध्ययनकर्ता बताते हैं, इस तरह ...पुणे पोर्श कांड: आरोपी नाबालिग के पिता-दादा की बढ़ी मुश्किलें, एक अन्य केस दर्ज हुआ ...
पुणे। महाराष्ट्र के पुणे पोर्श कांड में आरोपी नाबालिग और उसके परिवार की मुश्किलें कम होती नजर नहीं आ रही है। आरोपी ...भाजपा को समर्थन के बदले JDU और TDP की क्या होगी डिमांड, जानिए यहां…
नई दिल्ली। लोकसभा चुनाव का रिजल्ट आने के बाद अब एनडीए सरकार बनाने की कवायद कर रही है। मीडिया रिपोर्टस की मानें ...टी20 वर्ल्ड कप में भारत का पहला मैच…कब, कहां और कैसे देखें, जानिए यहां
नई दिल्ली। भारत और आयरलैंड के बीच मैच आज यानी पांच जून को खेला जाने वाला है। भारतीय टीम टी-20 वर्ल्ड कप में ...पीएम मोदी के किन नेताओं को मिली हार, किसके हाथ लगी जीत, जानिए एक क्लिक ...
नई दिल्ली। लोकसभा चुनाव के नतीजे काफी हद तक साफ हो चुके हैं। 543 सीटों में से 542 सीटों पर काउंटिंग हुई। ...क्या राम मंदिर, राशन और मोदी की गारंटी BJP के काम न आई, जानिये फेल ...
Lok Sabha Election: लोकसभा चुनाव के अब तक आए रुझानों में एक बात तो साफ है कि बीजेपी नेतृत्व ने 2024 के ...